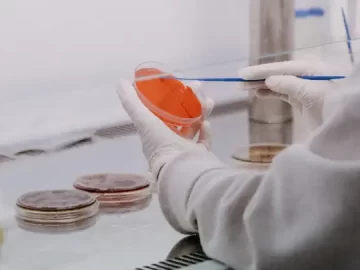
El primer análisis sobre la muestra de viruela del mono en el país dio positivo
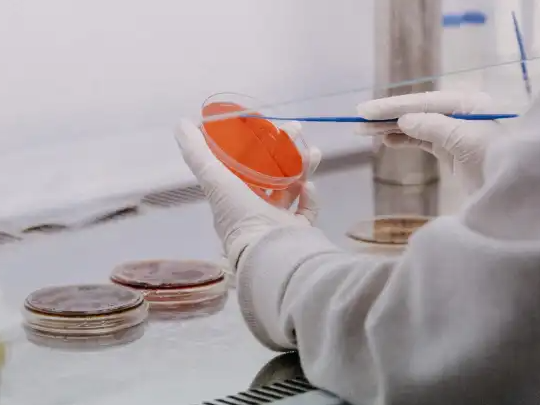
El primer análisis sobre la muestra de viruela del mono en el país dio positivo

Según el primer estudio que realizó el Instituto Nacional de Enfermedades Infecciosas ANLIS “Dr. Carlos G. Malbrán”, la muestra del paciente argentino que volvió de España sería compatible con viruela del mono.
“El primer resultado obtenido a partir de las muestras de contenido vesicular correspondientes al caso sospechoso informado en el día de ayer determinó la presencia de partículas virales compatibles con Poxvirus del género Orthopox, un virus que no circula en la Argentina, y que presenta una alta probabilidad de compatibilidad con viruela símica”, se lee en un comunicado que difundió el Ministerio de Salud.
El paciente se encuentra en buen estado general y en “aislamiento” en la Ciudad de Buenos Aires. Estuvo en España entre el 28 abril y el 16 de mayo 2022 y se acercó a un centro de salud cuando comenzó a sentir los primeros síntomas.
Por otro lado, las jurisdicciones correspondientes están realizando el seguimiento epidemiológico de los contactos estrechos del caso, que hasta el momento se encuentran todos asintomáticos.
Cómo es el estudio que realizó el Malbrán para detectar el virus
Según lo que informó la cartera sanitaria, el estudio se realizó con la técnica de coloración negativa para microscopía electrónica, lo que determinó la presencia de partículas virales compatibles con Poxvirus pertenecientes al género Orthopox. En cambio, no se halló la presencia de virus del género Parapox, así como tampoco otros tipos virales productores de lesiones similares (Herpes, Varicela, Enterovirus).
Al mismo tiempo, se realizó una reacción de amplificación por PCR para el gen de la hemaglutinina viral que se encuentra en proceso, cuyo producto debe ser sometido a secuenciación genética por el método Sanger para identificar el virus a nivel especie.
Viruela del mono: cuáles son las recomendaciones del Ministerio de Salud
Toda persona que presente síntomas compatibles (en especial erupciones) y antecedentes de viaje a zonas donde está habiendo casos y/o supone alguna exposición de riesgo con casos sospechosos, probables o confirmados, deberá tomar medidas de aislamiento social (no concurrir a escuela, trabajo, eventos sociales, etc), implementar medidas de protección respiratoria (uso adecuado de barbijo, ambientes ventilados y distancia de las otras personas) y realizar la consulta con el sistema de salud de forma inmediata.
Se considera exposición a un caso si:
● Ha presentado exposición sin protección respiratoria (particularmente relevante para los trabajadores de la salud).
● Contacto físico directo, incluido el contacto sexual.
● Contacto con materiales contaminados como ropa o ropa de cama o toallas.
Si una persona ha tenido contacto de riesgo con un caso sospechoso o confirmado de viruela símica en el período infeccioso -comprendido entre el inicio de síntomas del caso hasta que hayan caído todas las costras de las lesiones cutáneas- deberá guardar los siguientes cuidados:
● Control su temperatura dos veces al día.
● Mientras permanezca asintomática, puede continuar con las actividades diarias de rutina, pero debe permanecer cerca de su casa mientras dure la vigilancia.
● Se realizará seguimiento clínico-sanitario estricto durante 21 días desde el último contacto con el caso
● Si la persona desarrolla erupción, deberá ser aislada y evaluarse como caso sospechoso, además se debe recolectar una muestra para análisis de laboratorio para detectar viruela símica.
● No debe donar sangre, células, tejidos, órganos, leche materna o semen mientras estén bajo vigilancia de síntomas.
● En caso de niños en edad preescolar se recomienda evitar que acudan a guarderías u otros entornos grupales.
Fuente: TN